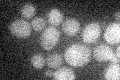
YOR237W
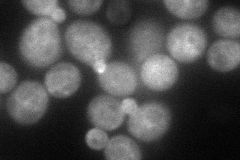
YOR237W
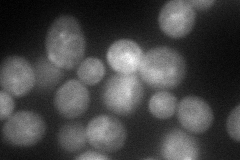
YOR237W
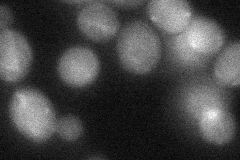
YOR237W
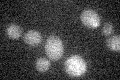
YOR237W

View description
Protein implicated in the regulation of ergosterol biosynthesis; one of a seven member gene family with a common essential function and non-essential unique functions; similar to human oxysterol binding protein (OSBP)
Localization:
Intensity:
Fold change:
Significance:
-
C’ GFP library in SD
below threshold18.02 -
N' NOP1pr-GFP in SD
punctate,vacuole membrane,bud80.4268 -
N' TEF2pr-mCherry in SD
ER,punctate,bud81.3513 -
N' NATIVEpr-GFP in SD

below threshold20.3459 -
N' TEF2pr-VC and Cyto-VN in SD
cytosol36.3348 -
C’ GFP library in SD+DTT

cytosol14.790.82No -
C’ GFP library in SD+H2O2

cytosol18.051No -
C’ GFP library in Starvation Media
cytosol14.910.82No -
C’ GFP library on the background of Pup2-DaMP

below threshold -
C’ GFP library on the background of CCT mutant

below threshold16.89840.937157No
